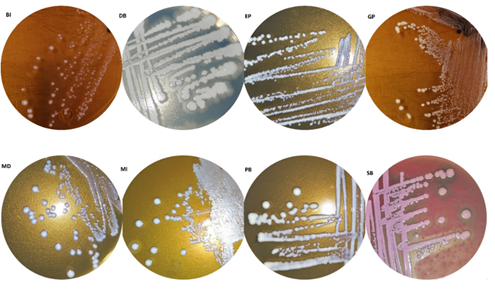
Un pastel de chocolate

Descripción generada automáticamente con confianza baja

Microorganismos electroactivos en el agua residual de beneficiado de café (procesos redox de hierro)
Joice Castro
Alvarez1
, Lidieth Uribe Lorío2
&
Paola Fuentes-Schweizer3,
4![]()
1. Universidad de Costa Rica, Sede Occidente, Departamento de Ciencias Naturales, Sección Química, San Ramón, Alajuela, Costa Rica; joice.castro@ucr.ac.cr
2. Universidad de Costa Rica, Centro Investigaciones Agronómicas, Laboratorio Microbiología Agrícola; Facultad de Ciencias Agroalimentarias, Escuela de Agronomía, San Pedro, San José, Costa Rica; lidieth.uribe@ucr.ac.cr,
3. Universidad de Costa Rica, Facultad de Ciencias, Escuela de Química, San Pedro, San José, Costa Rica; paola.fuentes@ucr.ac.cr
4. Universidad de Costa Rica, Centro de Investigaciones en Electroquímica y Energía Química, San José, Costa Rica
Recibido 12-VI-2023 ● Corregido 30-VII-2023 ● Aceptado 07-VIII-2023
DOI: https://doi.org/10.22458/urj.v16i1.4806
|
ABSTRACT. “Electroactive
microorganisms in coffee processing wastewater (iron redox processes).” Introduction: Wastewater is often
a good source for electrogenic bacteria, which are essential for Microbial
Fuel Cells (MFCs). The electrons they release while metabolizing organic
matter is evidence of their electrogenic capacity. Objective: To
evaluate the iron-reducing capacity of bacteria isolated from coffee
wastewater. Methods: We isolated morphologically distinct facultative
bacteria from the anode electrode of MFCs, with coffee mill wastewater as our
substrate. We did a preliminary identification with the Biolog GEN III system
(Biolog Inc. Hayward, CA, USA). To assess the conversion of iron (III) to
iron (II) by the isolated bacteria, we tested iron (III) citrate, iron (III)
chloride, and iron (III) oxide. For comparison, we used S. oneidensis
as a positive control in our experiments. Results: We identified eight
bacterial isolates with a predominance of non-sporulated Gram positive
bacilli morphology. They have reductive activity of iron compounds, giving
the best conversion percentages from
Keywords: Microbial Fuel Cell, electrogenic, bacteria, wastewater, iron reduction.
|
RESUMEN. Introducción: Las aguas
residuales a menudo son una buena fuente de bacterias electrogénicas,
esenciales para las Celdas
Microbianas de Combustible (CMC). Los
electrones que liberan al metabolizar la materia orgánica son evidencia de su
capacidad electrogénica. Objetivo: Evaluar la capacidad de reducción
de hierro de las bacterias aisladas de las aguas residuales del café. Métodos: Aislamos del electrodo del ánodo de las CMC
bacterias facultativas morfológicamente diferentes, utilizando agua residual
de un beneficio de café como sustrato. A estas bacterias les realizamos una
identificación preliminar por el sistema Biolog GEN III (Biolog Inc. Hayward,
CA, EE. UU.). Determinamos el porcentaje de conversión de
Palabras clave: Celdas Microbianas de Combustible, electrogénico, bacteria, agua residual, reducción hierro. |
La creciente demanda de fuentes de energía limpia y la necesidad de una correcta disposición de residuos industriales y domésticos de origen orgánico, ha proyectado a las Celdas Microbianas de Combustible (CMC) como una tecnología de gran potencial para cumplir ambos propósitos, al ser un sistema bioeléctrico en el que las bacterias transforman en energía eléctrica la energía química almacenada en los compuestos orgánicos (Obileke et al., 2021; Palanisamy et al., 2019; Santoro et al., 2017). Las CMC contienen un ánodo y un cátodo, en el ánodo se da, bajo condiciones anaerobias, la oxidación de materia orgánica por parte de bacterias, liberando electrones a través de sus cadenas respiratorias hacia el electrodo del ánodo que se movilizan por medio de cables conductores de electricidad hacia el electrodo del cátodo (Liu et al., 2018), que puede estar en un compartimiento con una disolución catódica (Figura 1A) o ser un electrodo expuesto al aire (Figura 1B) (Kumar et al., 2019).

Fig. 1. Diagramas de dos tipos de celda microbiana de combustible (CMC). A) CMC de dos
compartimientos con cámara anódica y catódica. B) CMC de un compartimiento con electrodo del
cátodo al aire. Elaboración propia.
Esta capacidad electrogénica de las bacterias ha supuesto una interesante posibilidad para aplicaciones sostenibles, como la obtención de energías limpias y el tratamiento de residuos y contaminantes (Gildemyn et al., 2017; Gu, 2003; Hong & Gu, 2010; Rosenbaum & Henrich, 2014; Yasri et al., 2019).
El aislamiento de bacterias electrogénicas se ha realizado en diferentes ambientes y se han probado en un gran número de sustratos, como las aguas residuales de la agricultura (Ha et al., 2012), de la cervecería (Feng et al., 2008; Wen et al., 2009), de la industria del chocolate (Patil et al., 2009), por mencionar algunos ejemplos (Gude, 2016). Este origen tan diverso ha permitido el aislamiento de una gran diversidad de géneros de bacterias con capacidad de transferir los electrones, generados del proceso metabólico, al electrodo del ánodo de la CMC; bacterias como la Shewanella oneidensis se ha estudiado ampliamente y se emplea como bacteria modelo para sistemas de transferencias de electrones.
La S. oneidensis tiene la capacidad de reducir compuestos solubles de manera directa por medio de citocromos tipo c expuestos en la superficie celular (Breuer et al., 2015; Fennessey et al., 2010), además se ha observado que la bacteria tiene la capacidad de reducir compuestos sólidos como el óxido de hierro (III) y que el proceso no se realiza de forma directa como se había creído por mucho tiempo, si no que la reducción se da por un proceso complejo, que incluye la producción de sideróforos que permiten la solubilización de estos óxidos insolubles (Fennessey et al., 2010).
Las aguas residuales del beneficiado de café como nicho para la búsqueda, de bacterias electrogénicas, es prometedora, ya que este sustrato presenta una alta carga orgánica con capacidad para emplearse en CMC y obtener energía eléctrica como valor agregado durante su tratamiento biológico. Además, un factor importante a considerar es el pH que presenta el agua residual de este proceso (pH 3-5) (Cárdenas et al., 2022), lo que limita las especies bacterianas capaces de vivir en esas condiciones. Así, el empleo de bacterias electrogénicas nativas, adaptadas a las condiciones de las aguas residuales beneficiaría el proceso, ya que uno de los factores más importantes para un buen rendimiento en las CMC es que las bacterias sean capaces de degradar el sustrato disponible (Obileke et al., 2021). Se han tenido indicios de bacterias electrogénicas presentes en aguas residuales de café, lo que motiva un estudio más amplio de la microbiota de este sustrato (Cárdenas et al., 2022; Castro, 2019).
Esta
investigación evalúa la capacidad reductora de las bacterias en tres diferentes
compuestos de hierro (III) por parte de bacterias aisladas del electrodo del
ánodo de CMC provenientes de agua residual del beneficiado de café. La capacidad de las bacterias de reducir
sería una evidencia de la posibilidad de liberar
electrones al metabolizar la materia orgánica y generar energía eléctrica en
una CMC.
MATERIALES Y MÉTODOS
Aislamiento de las CMC: Utilizamos agua residual de café procedente del beneficio de Coopetarrazú recolectada la noche antes de la implementación de las CMC, tamizamos el agua y la almacenamos en congelación a -17 °C hasta su uso. Empleamos CMC de dos compartimentos separados por una membrana semipermeable (Nafion®). Utilizamos electrodos en forma de hisopos de fibra de grafito en el ánodo, en el caso del cátodo se usó tela de grafito de forma circular.
Para el aislamiento de las bacterias realizamos dos ensayos en las CMC en enero, 2021 (tres CMC) y febrero, 2021 (dos CMC). En el ánodo colocamos agua residual del beneficiado de café (120mL) a temperatura ambiente en un sistema anaerobio y en el cátodo 120 mL de amortiguador de sales de fosfato (pH= 7), la duración del ensayo fue de cinco días. Aislamos las bacterias presentes en el electrodo del ánodo, en cámara de flujo laminar utilizando hisopo estéril. Se muestreó la superficie del electrodo del ánodo y se rayó en medio de cultivo. Empleamos los medios Agar MRS, Agar Nutritivo, Agar MacConkey y medio agar Pseudomonas cetrimida; incubamos inicialmente en una jarra de anaerobiosis Thermo Scientific™ Oxoid de 2,5 litros y una vez puras se crecieron en condiciones aerobias con el fin de seleccionar bacterias anaerobias facultativas.
Caracterización del sustrato: Para realizar el análisis de DQO utilizamos el equipo de la casa comercial HATCH y suplementos de la casa comercial Wissenschaftlich-Technische Werkstätten (WTW), empleando el reactor modelo DRB 200 de HACTH Company con tubos de reactivo para un rango de concentración de 0-1500mg/L DQO de WTW. Como disolución patrón utilizamos ftalato ácido de potasio (KHP) (1,224g/mL), y como blanco agua destilada. Para la determinación de azúcares simples enviamos las muestras al laboratorio Químico de Alimentos del Centro Nacional de Ciencia y Tecnología de Alimentos (CITA) de la Universidad de Costa Rica. La determinación de contenido de lignina, celulosa y hemicelulosa fue realizada por Centro de Investigación en Nutrición Animal (CINA) de la Universidad de Costa Rica.
Identificación de los aislamientos bacterianos: A los aislamientos puros se les realizaron pruebas de Gram, catalasa y oxidasa y se identificaron preliminarmente a nivel de género mediante el sistema Biolog GEN III (Biolog Inc. Hayward, CA, EE. UU.), siguiendo las instrucciones del fabricante. El procedimiento de inoculación se basó en el método original de microplaca GEN III (BiologTM). Transferimos las colonias bacterianas al fluido de inoculación A (IFA) con un hisopo de algodón estéril para generar suspensiones de células bacterianas, cuya transmitancia se ajustó entre 80% y 90% mediante un turbidímetro (BiologTM). Luego, dispensamos 100µL de la suspensión celular en cada pocillo. Leímos la absorbancia de cada pocillo de las microplacas inoculadas a 590nm en un Biolog (Biologic MicroStation™), a 24h y 48h. Los resultados se interpretaron con el software del sistema de identificación (base de datos GEN III, versión 2.8.0). Cuando no fue posible la identificación con el Biolog, utilizamos el sistema VITEK® MS (BIOMÉRIEUX) para lo cual enviamos las muestras a la Facultad de Microbiología de la Universidad de Costa Rica.
Prueba
de reducción de Fe (III): Empleamos una
disolución base que contiene:
(0,46g/L),
(0,12g/L),
(0,22g/L),
(40g/L) y
(42 g/L) a la que le agregamos 5mL/L de una disolución de
minerales que contiene:
(0,11g/L),
(0,17g/L),
(0,13g/L),
(0,036g/L),
(0,0055g/L),
(0,0054g/L),
(0,13g/L),
(0,022g/L) y 5mL/L de una disolución de vitaminas que contiene:
Vitamina B6 (0,021g/L), hidrocloruro de tiamina (0,012g/L), ácido nicotínico
(0,0054g/L), vitamina B12 (0,0001g/L), ácido para-aminobenzoico
(0,011g/L); como fuente de carbono se empleó una disolución de glucosa
(0,25mol/L). Para las pruebas utilizamos disoluciones de: FeCl3
(0,020mol/L), citrato de hierro (III) (0,020mol/L) y óxido de hierro (III)
aproximadamente (0,00100g) como fuentes de iones
.
Los
ensayos los realizamos por triplicado empleando 8mL del medio (disolución base
con vitaminas y minerales), 3,2mL de la disolución de glucosa, 4,0mL de la
disolución de hierro (III), en el caso de los ensayos con óxido de hierro (III)
agregamos el sólido y 4mL de agua; por último, inoculamos con 800μL de la
bacteria crecida por 24h en medio LB, generamos un ambiente anaerobio
burbujeando
por un periodo de 5 min; con un pH entre 6-7 en los
ensayos. Como control negativo utilizamos las mismas cantidades mencionadas
anteriormente y sustituimos el volumen del inóculo por agua. Realizamos un
segundo control de crecimiento de inóculo bajo las mismas condiciones que en
los demás ensayos, pero sin el compuesto de hierro. Como control positivo
utilizamos S. oneidensis por ser una bacteria electrogénica,
reemplazando la glucosa por lactato de sodio (0,2 mol/L) como fuente de
carbono. El experimento permaneció a 30°C durante 5 días, con una agitación
diaria.
Determinamos el crecimiento bacteriano mediante la densidad óptica de los cultivos medida en equipo espectrofotómetro UV-Vis (Thermo Scientific™ Evolution 201) por triplicado con celdas de plástico con camino óptico de 1cm y una longitud de onda de 600nm.
Análisis de datos: La cantidad de hierro (II) generada por cada una de las bacterias, fue determinada utilizando el método colorimétrico hierro-ortofenantrolina, empleando una curva de siete patrones (0,1-1,5mg/L). Realizamos las mediciones en un equipo espectrofotómetro UV-Vis (Thermo Scientific™ Evolution 201) con celdas de plástico con camino óptico de 1cm y con una longitud de trabajo de 510nm.
Con los patrones realizamos una curva de calibración de la absorbancia versus la concentración y calculamos la línea de mejor ajuste, interpolando en esta obtuvimos las concentraciones de hierro (II), realizamos la corrección del control negativo. Calculamos el porcentaje de conversión de hierro (III) a hierro (II). Para las pruebas estadísticas usamos R (versión 4.0.2) y R Studio (versión 2021.09.2+382). Para la elaboración de los gráficos utilizamos las librerías ggplot, dplyr, hrbrthemes y viridis. Con la librería agricolae realizamos el análisis de varianza (ANOVA) de dos colas y la prueba HSD de Tukey.
RESULTADOS
Caracterización de agua residual de Café: La Tabla A1 (apéndice) muestra que el agua residual del beneficiado de café presenta una demanda química de oxígeno alta, lo que implica una gran cantidad de materia orgánica disponible, siendo mayormente material fibroso, además el agua residual presenta un pH ácido.
Identificación de los aislamientos bacterianos: Obtuvimos ocho morfotipos bacterianos (Figura 2), de los cuales cinco corresponden a bacilos Gram positivos no esporulados, coincidentes con los géneros Weissella (MD), Lactobacillus (GP, PB, EP) y una bacteria ácido láctica (BAL) no identificada; un bacilo Gram positivo esporulado correspondiente a Bacillus (DB), un coco Gram positivo coincidente con genero Aerococcus (BI) y un bacilo Gram negativo identificado como Citrobacter (SB) (Tabla 1).
Fig. 2. Aislamientos provenientes del agua residual del beneficiado de café, recolectados del ánodo
de la CMC. BI, EP, GP, MD, MI, PB en medio MRS; SB en medio MacConkey; DB en agar nutritivo.
Tabla 1
Caracterización e identificación de los aislamientos provenientes del agua residual del beneficiado de café, recolectados del ánodo de la CMC
|
Aislamiento |
Caracterización |
Identificación |
||
|
Catalasa |
Oxidasa |
Morfología |
||
|
MI |
- |
- |
Bacilo Gram positivo |
BAL |
|
BI |
- |
- |
Coco Gram positivo |
Aerococcus sp. |
|
MD |
- |
- |
Bacilo Gram positivo |
Weissella sp. |
|
GP |
- |
- |
Bacilo Gram positivo |
Lactobacillus sp. |
|
EP |
- |
- |
Bacilo Gram positivo |
Lactobacillus sp. |
|
PB |
- |
- |
Bacilo Gram positivo |
Lactobacillus sp. |
|
DB |
+ |
- |
Bacilo Gram positivo, esporulado |
Bacillus sp. |
|
SB |
- |
- |
Bacilo Gram negativo |
Citrobacter sp. |
|
BI, EP, GP, MD, MI, PB en medio MRS; SB en medio MacConkey; DB en Agar nutritivo. BI, Gp, EP, PB se identificaron por sistema Biolog GEN III; DB, SB, MI se identificaron por sistema VITEK® MS (BIOMÉRIEUX) |
||||
Reducción de compuestos de hierro por parte de las bacterias aisladas: Mostramos en Figura 3a y 3b que, en la mayoría de los casos, las bacterias crecieron más en el medio control, que no contiene los compuestos de citrato de hierro (III) y cloruro de hierro (III), este comportamiento no se cumplió para S. oneidensis y la bacteria SB, las cuales crecieron mejor en presencia de hierro. Por otro lado, como observamos en la Figura 3c, el crecimiento de las bacterias en el medio en ausencia y presencia de óxido de hierro (III) fue similar. Las Figuras 3a, 3b y 3c, muestran que el crecimiento de la S. oneidensis fue mucho menor al de las otras bacterias, tanto en el medio control como en el medio con los compuestos de hierro.
Las comparaciones
mostradas en la Figura 4, se realizan sobre los datos de conversión sin
normalizar, ya que no era posible hacer una estandarización en este estudio. La
Figura 4a muestra que el porcentaje de conversión de
a
en el citrato, fue significativamente superior (p<0,05)
para S. oneidensis, a pesar del poco crecimiento observado. Asimismo, se
destaca que la bacteria EP presenta una de las mayores conversiones de
a
, entre las bacterias aisladas, al utilizar citrato de hierro (III)
como fuente de hierro.
En cuanto a la
conversión de
a
en el
cloruro de hierro (III), mostrada en la Figura 4b, las bacterias se clasifican
en tres grupos significativamente diferentes según la prueba de Tukey (Figura 4b),
siendo el aislamiento SB el que presentó una conversión significativamente
mayor a las demás bacterias (p<0,05). Los aislamientos GP y PB también
logran una conversión significativamente mayor a las otras seis bacterias.
Al utilizar óxido de hierro (III) como fuente de hierro
(III), únicamente el aislamiento SB muestra una reducción de
a
significativamente
diferente (p<0,05) y superior a las demás bacterias (Figura 4c), conviene
resaltar que los crecimientos en este sustrato fueron similares para todas las
bacterias, únicamente la S. oneidensis presenta un crecimiento muy bajo
comparado al resto (Figura 3c).

Fig. 3. Comparación de crecimiento de las bacterias en presencia de diferentes compuestos de hierro. Ensayo con a) citrato de hierro (III), b) cloruro de hierro (III) y c) óxido de hierro (III). Cada barra de error (n=3) se presenta con un nivel de confianza del 95%.

Figura
4. Conversión de
a
por
parte de las bacterias aisladas en los diferentes compuestos de hierro
empleando medio mínimo. Porcentaje de conversión de las bacterias en a) citrato
de hierro (III). b) cloruro de hierro (III). c) óxido de hierro (III). Cada barra de error (n=3) se presenta con un nivel de
confianza del 95%. Valores promedios se muestran con el límite de confianza
al 95%. Valores con diferentes letras denotan diferencia significativa en cada
ensayo con p<0,05 (HSD Tukey).
En la Tabla A2 (apéndice) presentamos la conversión
de
a
para cada
bacteria en los tres sustratos de hierro (III) empleados. El análisis de
varianza que realizamos para comparar el % de reducción de cada especie en los
tres compuestos de hierro, indica que las bacterias DB, MI y PB presentan un
comportamiento semejante para los tres compuestos de hierro, sin mostrar una
inclinación particular. Por otra parte, las bacterias GP, MD y SB muestran una
predilección por reducir el óxido de hierro (III) presentando valores
significativamente superiores (p<0,05) para este compuesto.
Por otra parte, el aislamiento BI presenta valores de
reducción de
a
significativamente diferentes para los tres compuestos de hierro (III), con el
mayor porcentaje de reducción sobre el óxido de hierro (III). De manera similar
ocurre en el caso de EP y S. oneidensis, quienes muestran procentajes de
conversiones significativamente diferentes para todos los compuestos empleados,
con los mayores porcentajes de reducción para el citrato de hierro (III).
DISCUSIÓN
El agua residual del beneficiado de café tiene mucha materia orgánica que las bacterias podrían emplear para sus procesos metabólicos, sin embargo, al analizar el tipo de carbohidrato presente resalta que los azúcares sencillos, que son los que emplean mayormente las bacterias, son escasos en este residuo (Sánchez-Santillán & Cobos-Peralta, 2016; Viviano et al., 2011). Observamos una gran cantidad de contenido fibroso que no todo tipo de microorganismo es capaz de degradar (Sánchez-Santillán & Cobos-Peralta, 2016; Viviano et al., 2011), lo que, sumado al hecho de que el agua residual tiene un pH ácido, explica la poca variabilidad de microorganismos aislados.
Por otro lado, al aislar específicamente microorganismos anaerobios facultativos, disminuyó la cantidad de géneros aislados. La mayoría de los géneros encontrados están relacionados entre sí, Aerococcus, Weissellla y Lactobacilus son parte de las BAL, que poseen capacidad de crecimiento en condiciones ácidas (Carr et al., 2002; Erkmen, 2022). Estos hallazgos son congruentes con investigaciones anteriores donde se lograron aislar bacterias del género Lactobacillus y Enterobacter en este tipo de sustrato (Castro, 2019; Villegas, 2020).
Del género Lactobacillus se han encontrado varias especies con capacidades electrogénicas como L. bulgaricus (Arbianti et al., 2013); L. pentosus (Vilas et al., 2019), L. casei y paracasei (Darmawan et al., 2018; Nastro et al., 2015), L. plantarum (Ganzorig et al., 2023); L. reuteri y L. rhamnosus (Tahernia et al., 2020); lo que respalda el hallazgo de bacterias con capacidades electrogénicas en los aislamientos analizados.
Al analizar la
conversión de
a
por parte
de las bacterias, usando como fuente de hierro el citrato se deben tener
algunas consideraciones, primeramente que el citrato es uno de los quelantes
más empleados por bacterias en la captación de hierro (III) para la realización
de sus funciones vitales, se conoce que el hierro está involucrado en muchos
procesos fundamentales de las bacterias y de otros organismos (Banerjee et al., 2016).
Por otro lado es
importante tener presente que el complejo
-citrato es
dependiente del pH del medio en que se encuentra, investigaciones han mostrado
que a valores neutros de pH el complejo se presenta principalmente como
[Fe(Cit)2]5- un ion de tamaño medio (
en
comparación a otras formas del complejo
-citrato (Fukushima
et al., 2012; Gautier-Luneau et al., 2005; Vukosav et al., 2012).
Las bacterias DB, EP,
SB, MI y PB muestran un mejor crecimiento en presencia de citrato de hierro
(III), lo que a su vez se refleja en la capacidad reductiva que presentan,
aunque el porcentaje de conversión de
a
no es tan
alto comparado con la conversión mostrada por S. oneidensis. Este
comportamiento puede deberse a la absorción de una porción del citrato de
hierro (III) por parte de estas bacterias, o a que la forma del complejo les
dificulte la conversión, lo que contrasta con S. oneidensis la cual ha
mostrado una capacidad reductiva muy eficiente en presencia de citrato de
hierro (III) (Bennett
et al., 2015; Coursolle & Gralnick, 2010).
S. oneidensis utiliza un tipo de intercambio de electrones directo y externo facilitado desde el interior de la célula, donde los electrones generados en el metabolismo son movilizados por la menaquinona (coenzima) al complejo citocrómico CymA ubicado en el lado interno de la membrana, los electrones se transfieren desde este punto a MtrA (citocromo periplasmático) y finalmente a citocromos terminales MtrC y Omc que reducen el citrato de hierro por contacto directo (Liu et al., 2020; Yin et al., 2022).
Para comprender los
resultados obtenidos en la conversión de
a
por parte
de las bacterias, al utilizar como fuente el cloruro de hierro (III), es
importante tomar en cuenta que, en ambientes acuosos, el cloruro de hierro
forma una esfera de hidratación que según la concentración, puede llegar a
presentar una doble capa acuosa que puede constar de seis moléculas de agua en
la primera esfera y cinco más en la segunda con la presencia de un ion cloruro (Persson,
2018; Smirnov & Grechin, 2019).
Esta conformación, podría limitar la reducción del hierro por las bacterias ya sea por método directo de entrega de electrones, o por mecanismos como el uso de mediadores o estructuras como pilis bacterianos (Thapa et al., 2022), esto podría explicar por qué las bacterias BI, DB, EP, MD, MI y S. oneidensis presentan una conversión baja para este compuesto a pesar de su solubilidad. Sin embargo, es importante señalar que, bajo las mismas condiciones, las bacterias GP, PB y SB lograron reducir mayor cantidad el cloruro de hierro (III) que las demás bacterias, siendo SB la que presentó mejor porcentaje de conversión, esto podría indicar que el método de transferencia de electrones en estas bacterias es más eficiente.
Los mejores
rendimientos de reducción de
a
se dieron
con el Fe2O3 que es un sólido poco soluble. Según las
pruebas de Tukey para este ensayo, observamos que únicamente la bacteria SB
logró un rendimiento significativamente diferente a las demás, estos resultados
nos indican que las bacterias tienen la capacidad de reducir productos
insolubles ya sea por transferencia directa de electrones, con mediadores o
solubilizando primero el óxido para su posterior reducción como se ha observado
en bacterias como S. oneidensis (Fennessey
et al., 2010; Kirchhofer et al., 2017; Thapa et al., 2022).
Si bien la bacteria S.
oneidensis pareciera tener bajo rendimiento en la reducción del
a
,
probablemente se deba a la poca biomasa obtenida por la bacteria durante el
estudio, lo que hace que la comparación de los resultados sin estandarizar no
permita visualizar un resultado fácilmente comparable con las demás bacterias
empleadas en el experimento. Esta bacteria se utiliza como control positivo, ya
que presenta distintos mecanismos para la reducción de compuestos (Beblawy
et al., 2018; Thapa et al., 2022).
Los resultados
obtenidos en los diferentes ensayos dan indicios de la capacidad de las
bacterias de liberar electrones al metabolizar la fuente de carbono empleada y
de esta forma lograr la reducción de
a
. Las
bacterias BI, EP, GP, MD, SB y S. oneidensis presentan en la conversión
de
a
valores
significativamente diferentes en al menos uno de los compuestos de hierro, lo
que podría implicar que el o los mecanismos empleados por estas cepas para
transferir electrones no es idóneo para todo tipo de compuesto. Las bacterias
BI, GP y MD presentaron muy bajos porcentajes de reducción de hierro en el
citrato, lo que podría ser evidencia de que se pudo dar una absorción de
citrato de hierro (III) por parte de estas bacterias; pero en el caso de óxido
de hierro (III) sus conversiones de hierro fueron significativamente mayores.
La bacteria SB presenta buen rendimiento en los tres compuestos estudiados y el
porcentaje de conversión de esta bacteria en estos compuestos es
significativamente diferente para los tres, viéndose más favorecida la
reducción de compuestos insolubles; esto podría indicar que al emplearse en una
CMC se daróa una buena transferencia de los electrones al ánodo, al realizar la
bacteria la oxidación de la materia orgánica.
La bacteria SB mostró los mejores rendimientos en la reducción de hierro, entre las bacterias estudiadas, esto puede deberse a la envoltura celular que posee, al ser una bacteria Gram negativa la existencia de estructuras proteínicas redox activas, por ejemplo citocromos, es más probable que en las demás bacterias, ya que estas estructuras no son tan comunes de observar en bacterias Gram positivas (Pankratova et al., 2019). De hecho los principales grupos de bacterias electroactivas que se han encontrado son Gram negativas (Ganzorig et al., 2023), esto no implica la ausencia de bacterias Gram positivas electroactivas, únicamente que en este tipo de microorganismos la transferencia de electrones se da mayormente por mediadores (Pankratova et al., 2019).
Los resultados indican que, dentro de los aislamientos, existen bacterias con capacidad electrogénica en el agua residual del beneficiado de café que podrían emplearse en la inoculación de las CMC en un estudio posterior. Bacterias como el aislamiento SB son buenas candidatas para emplearse en el tratamiento de agua residual del beneficiado de café y obtener energía eléctrica como valor agregado. Sin embargo, es importante identificar a nivel de especie la bacteria para tener más información que pueda permitir mejorar su implementación en CMC y entender un poco mejor el mecanismo de transferencia de electrones que emplea.
AGRADECIMIENTOS
Agradecemos a VICERRECTORÍA DE INVESTIGACIÓN de la Universidad de Costa Rica (UCR) por los fondos del proyecto 804-C1-079 que permitieron la realización de esta investigación, y el apoyo del programa de Maestría en Ciencia y Tecnología para la sostenibilidad del TEC, agradecemos al CELEQ, al Área de Microbiología Ambiental y Prospección Génica del Centro Investigación de Biología Celular y Molecular de la UCR por facilitar los equipos para el proyecto, agradecemos a la Ing. Fiorella Galiano y a M.Sc. Lorena Uribe por su orientación.
ÉTICA, CONFLICTO DE INTERESES Y DECLARACIÓN DE FINANCIAMIENTO
Declaramos haber cumplido con todos los requisitos éticos y legales pertinentes, tanto durante el estudio como en la preparación de este documento; que no hay conflictos de interés de ningún tipo y que todas las fuentes financieras se detallan plena y claramente en la sección de agradecimientos. Asimismo, estamos de acuerdo con la versión editada final de esta publicación. El respectivo documento legal firmado se encuentra en los archivos de la revista.
La declaración de contribución de cada autor es la siguiente: J.C.A., P.F.S., L.U.L.: Diseño del estudio, J.C.A. y P.F.S. Recolección de muestra. J.C.A. procesamiento de muestras y experimentación J.C.A. P.F.S. y L.U.L: análisis de datos, J.C.A. y P.F.S. preparación del manuscrito y todos las coautoras revisión y aprobación final del manuscrito.
REFERENCIAS
Arbianti, R., Utami, T. S., Hermansyah, H., Novitasari, D., Kristin, E., & Trisnawati, I. (2013). Performance Optimization of Microbial Fuel Cell (MFC) Using Lactobacillus bulgaricus. MAKARA Journal of Technology, 17(1), 32–38. https://doi.org/10.7454/mst.v17i1.1925
Banerjee, S., Paul, S., Nguyen, L. T., Chu, B. C. H., & Vogel, H. J. (2016). FecB, a periplasmic ferric-citrate transporter from E. coli, can bind different forms of ferric-citrate as well as a wide variety of metal-free and metal-loaded tricarboxylic acids. Metallomics, 8(1), 125–133. https://doi.org/10.1039/C5MT00218D
Beblawy, S., Bursac, T., Paquete, C., Louro, R., Clarke, T. A., & Gescher, J. (2018). Extracellular reduction of solid electron acceptors by Shewanella oneidensis. Molecular Microbiology, 109(5), 571–583. https://doi.org/10.1111/mmi.14067
Bennett, B. D., Brutinel, E. D., & Gralnick, J. A. (2015). A Ferrous Iron Exporter Mediates Iron Resistance in Shewanella oneidensis MR-1. Applied and Environmental Microbiology, 81(22), 7938–7944. https://doi.org/10.1128/AEM.02835-15
Breuer, M., Rosso, K. M., Blumberger, J., & Butt, J. N. (2015). Multi-haem cytochromes in Shewanella oneidensis MR-1: structures, functions and opportunities. Journal of The Royal Society Interface, 12(102), 20141117. https://doi.org/10.1098/rsif.2014.1117
Cárdenas, D., Villegas, J. R., Solís, C., Sanabria-Chinchilla, J., Uribe, L., & Fuentes-Schweizer, P. (2022). Evaluación del desempeño de una celda de combustible microbiana con electrodo de grafito modificado para el tratamiento de agua residula del procesamiento de café. Revista Colombiana de Química 51(1), 40–47. https://doi.org/10.15446/rev.colomb.quim.v51n1.101185
Castro, J. (2019). Búsqueda de bacterias electrogénicas en celdas de combustible microbiano a partir de miel de café. [Tesis de Licenciatura, Universidad de Costa Rica]. http://repositorio.sibdi.ucr.ac.cr:8080/xmlui/handle/123456789/6438
Coursolle, D., & Gralnick, J. A. (2010). Modularity of the Mtr respiratory pathway of Shewanella oneidensis strain MR-1. Molecular Microbiology, 77(4), 995-1008. https://doi.org/10.1111/j.1365-2958.2010.07266.x
Darmawan, M. D., Hawa, L. C., & Argo, B. D. (2018). Performance of microbial fuel cell double chamber using mozzarella cheese whey substrate. IOP Conference Series: Earth and Environmental Science, 131, 012047. https://doi.org/10.1088/1755-1315/131/1/012047
Feng, Y., Wang, X., Logan, B. E., & Lee, H. (2008). Brewery wastewater treatment using air-cathode microbial fuel cells. Applied Microbiology and Biotechnology, 78(5), 873–880. https://doi.org/10.1007/s00253-008-1360-2
Fennessey, C. M., Jones, M. E., Taillefert, M., & DiChristina, T. J. (2010). Siderophores Are Not Involved in Fe(III) Solubilization during Anaerobic Fe(III) Respiration by Shewanella oneidensis MR-1. Applied and Environmental Microbiology, 76(8), 2425–2432. https://doi.org/10.1128/AEM.03066-09
Fukushima, T., Sia, A. K., Allred, B. E., Nichiporuk, R., Zhou, Z., Andersen, U. N., & Raymond, K. N. (2012). Bacillus cereus iron uptake protein fishes out an unstable ferric citrate trimer. Proceedings of the National Academy of Sciences, 109(42), 16829–16834. https://doi.org/10.1073/pnas.1210131109
Ganzorig, B., Zayabaatar, E., Pham, M. T., Marito, S., Huang, C.-M., & Lee, Y.-H. (2023). Lactobacillus plantarum Generate Electricity through Flavin Mononucleotide-Mediated Extracellular Electron Transfer to Upregulate Epithelial Type I Collagen Expression and Thereby Promote Microbial Adhesion to Intestine. Biomedicines, 11(3), 677. https://doi.org/10.3390/biomedicines11030677
Gautier-Luneau, I., Merle, C., Phanon, D., Lebrun, C., Biaso, F., Serratrice, G., & Pierre, J.-L. (2005). New Trends in the Chemistry of Iron(III) Citrate Complexes: Correlations between X-ray Structures and Solution Species Probed by Electrospray Mass Spectrometry and Kinetics of Iron Uptake from Citrate by Iron Chelators. Chemistry - A European Journal, 11(7), 2207–2219. https://doi.org/10.1002/chem.200401087
Gildemyn, S., Rozendal, R. A., & Rabaey, K. (2017). A Gibbs Free Energy-Based Assessment of Microbial Electrocatalysis. Trends in Biotechnology, 35(5), 393–406. https://doi.org/10.1016/j.tibtech.2017.02.005
Gu, J.-D. (2003). Microbiological deterioration and degradation of synthetic polymeric materials: recent research advances. International Biodeterioration & Biodegradation, 52(2), 69–91. https://doi.org/10.1016/S0964-8305(02)00177-4
Gude, V. G. (2016). Wastewater treatment in microbial fuel cells - An overview. Journal of Cleaner Production, 122, 287–307. https://doi.org/10.1016/j.jclepro.2016.02.022
Ha, P. T., Lee, T. K., Rittmann, B. E., Park, J., & Chang, I. S. (2012). Treatment of alcohol distillery wastewater using a bacteroidetes-dominant thermophilic microbial fuel cell. Environmental Science and Technology, 46(5), 3022–3030. https://doi.org/10.1021/es203861v
Hong, Y.-G., & Gu, J.-D. (2010). Physiology and biochemistry of reduction of azo compounds by Shewanella strains relevant to electron transport chain. Applied Microbiology and Biotechnology, 88(3), 637–643. https://doi.org/10.1007/s00253-010-2820-z
Kirchhofer, N. D., Rengert, Z. D., Dahlquist, F. W., Nguyen, T. Q., & Bazan, G. C. (2017). A Ferrocene-Based Conjugated Oligoelectrolyte Catalyzes Bacterial Electrode Respiration. Chem, 2(2), 240–257. https://doi.org/10.1016/j.chempr.2017.01.001
Liu, T., Luo, X., Wu, Y., Reinfelder, J. R., Yuan, X., Li, X., Chen, D., & Li, F. (2020). Extracellular electron shuttling eediated by soluble c -Type Cytochromes produced by Shewanella oneidensis MR-1. Environmental Science & Technology, 54(17), 10577–10587. https://doi.org/10.1021/acs.est.9b06868
Liu, X., Shi, L., & Gu, J-D. (2018). Microbial electrocatalysis: Redox mediators responsible for extracellular electron transfer. Biotechnology Advances, 36(7), 1815–1827. https://doi.org/10.1016/j.biotechadv.2018.07.001
Nastro, R. A., Falcucci, G., Toscanesi, M., Minutillo, M., Pasquale, V., Trifuoggi, M., Dumontet, S., & Jannelli, E. (2015). Performances and microbiology of a microbial fuel cell (MFC) fed with the organic fraction of municipal solid waste (OFMSW). Proceedings of the 6th European Fuel Cell - Piero Lunghi Conference, EFC 2015, November.
Obileke, K., Onyeaka, H., Meyer, E. L., & Nwokolo, N. (2021). Microbial fuel cells, a renewable energy technology for bio-electricity generation: A mini-review. Electrochemistry Communications, 125, 107003. https://doi.org/10.1016/j.elecom.2021.107003
Pankratova, G., Hederstedt, L., & Gorton, L. (2019). Extracellular electron transfer features of Gram-positive bacteria. Analytica Chimica Acta, 1076, 32–47. https://doi.org/10.1016/j.aca.2019.05.007
Patil, S. A., Surakasi, V. P., Koul, S., Ijmulwar, S., Vivek, A., Shouche, Y. S., & Kapadnis, B. P. (2009). Electricity generation using chocolate industry wastewater and its treatment in activated sludge based microbial fuel cell and analysis of developed microbial community in the anode chamber. Bioresource Technology, 100(21), 5132–5139. https://doi.org/10.1016/j.biortech.2009.05.041
Persson, I. (2018). Ferric Chloride Complexes in Aqueous Solution: An EXAFS Study. Journal of Solution Chemistry, 47(5), 797–805. https://doi.org/10.1007/s10953-018-0756-6
Rosenbaum, M. A., & Henrich, A. W. (2014). Engineering microbial electrocatalysis for chemical and fuel production. Current Opinion in Biotechnology, 29, 93–98. https://doi.org/10.1016/j.copbio.2014.03.003
Sánchez-Santillán, P., & Cobos-Peralta, M. A. (2016). Producción in vitro de ácidos grasos volátiles de bacterias celulolíticas reactivadas y bacterias ruminales totales en sustratos celulósicos. Agrociencia, 50(5), 565–574. http://tinyurl.com/ymsk2otk
Smirnov, P. R., & Grechin, O. V. (2019). Structure of the nearest surrounding of ions in aqueous solutions of iron(III) chloride by x-ray diffraction method. Journal of Molecular Liquids, 281, 385–388. https://doi.org/gpksff
Tahernia, M., Plotkin-Kaye, E., Mohammadifar, M., Gao, Y., Oefelein, M. R., Cook, L. C., & Choi, S. (2020). Characterization of Electrogenic Gut Bacteria. ACS Omega, 5(45), 29439–29446. https://doi.org/10.1021/acsomega.0c04362
Thapa, B. Sen, Kim, T., Pandit, S., Song, Y. E., Afsharian, Y. P., Rahimnejad, M., Kim, J. R., & Oh, S.-E. (2022). Overview of electroactive microorganisms and electron transfer mechanisms in microbial electrochemistry. Bioresource Technology, 347, 126579. https://doi.org/10.1016/j.biortech.2021.126579
Vilas, J., Oliveira, V. B., Marcon, L. R. C., Simões, M., & Pinto, A. M. F. R. (2019). Optimization of a single chamber microbial fuel cell using Lactobacillus pentosus: Influence of design and operating parameters. Science of The Total Environment, 648, 263–270. https://doi.org/10.1016/j.scitotenv.2018.08.061
Villegas, J. R. (2020). Uso de Celdas de Combustible Microbiano con cátodo al aire para el tratamiento del agua residual del procesamiento de café. [Tesis de Licenciatura, Universidad de Costa Rica]. http://tinyurl.com/ymab27uv
Viviano, F., Medina, L., Ramos, N., Amaíz, L., & Valbuena, O. (2011). Degradación de celulosa por bacterias de aguas termales de Las Trincheras, Venezuela. Revista Latinoamericana de Biotegnologia Ambiental y Algal, 2(1), 18–29. http://www.solabiaa.org/ojs3/index.php/RELBAA/article/view/25
Vukosav, P., Mlakar, M., & Tomišić, V. (2012). Revision of iron(III)–citrate speciation in aqueous solution. Voltammetric and spectrophotometric studies. Analytica Chimica Acta, 745, 85–91. https://doi.org/10.1016/j.aca.2012.07.036
Wen, Q., Wu, Y., Cao, D., Zhao, L., & Sun, Q. (2009). Electricity generation and modeling of microbial fuel cell from continuous beer brewery wastewater. Bioresource Technology, 100(18), 4171–4175. https://doi.org/b63sfh
Yasri, N., Roberts, E. P. L., & Gunasekaran, S. (2019). The electrochemical perspective of bioelectrocatalytic activities in microbial electrolysis and microbial fuel cells. Energy Reports, 5, 1116–1136. https://doi.org/ggdmvz
Yin, Y., Liu, C., Zhao, G., & Chen, Y. (2022). Versatile mechanisms and enhanced strategies of pollutants removal mediated by Shewanella oneidensis: A review. Journal of Hazardous Materials, 440, 129703. https://doi.org/10.1016/j.jhazmat.2022.129703
APENDICE
Tabla A1
Caracterización del agua residual de café empleada para el aislamiento de las posibles bacterias electrogénicas.
|
Parámetro |
Resultado |
|
|
Demanda Química de Oxígeno |
(70000 ± 700) mg O2/L |
|
|
Azúcares simples |
Glucosa |
(1,52 ± 0,02) g/100 mL |
|
Fructuosa |
(0,49 ± 0,08) g/100 mL |
|
|
Celulosa |
(50,8 ± 2,2) g/100 g |
|
|
Hemicelulosa (Xilano) |
(8,5 ± 0,2) g/100 g |
|
|
Lignina |
(18,5 ± 0,5) g/100g |
|
|
pH |
< 4,0 |
|
Tabla A2
Comparación de porcentaje de conversión de hierro (III) a hierro (II) por cada bacteria para los diferentes compuestos de hierro empleados
|
Aislamiento |
% conversión FE (III) A FE (II) |
||
|
Citrato de hierro (III) |
Cloruro de hierro (III) |
Óxido de hierro (III) |
|
|
BI |
-0,50c |
0,09b |
1,22a |
|
DB |
1,33a |
0,07a |
1,00a |
|
EP |
1,95a |
0,08c |
1,48b |
|
GP |
-0,10b |
0,59b |
1,74a |
|
MD |
-0,28b |
0,10ab |
0,75a |
|
MI |
0,50a |
0,08a |
1,74a |
|
PB |
0,60a |
0,58a |
1,40a |
|
SB |
1,80b |
1,01b |
4,26a |
|
S. oneidensis |
3,36a |
0,07c |
0,68b |
|
Diferentes letras denotan diferencia significativa entre las conversiones de hierro en los diferentes compuestos por cada bacteria con p<0,05, analizado por HSD Tukey. |
|||